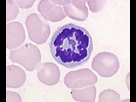
https://image.noelshack.com/fichiers/2019/50/6/1576335946-capture-d-ecran-2019-12-14-a-16-05-06.jpg

[Officiel] Les Jean-PACES 2019/2020
Le 13 décembre 2019 à 16:46:45 Jean-Passe-Hess a écrit :
Au ccb il a dit faux
Ah bah alors j’ai pas fait d’erreur en ne le prenant pas. Mais du coup pourquoi c’est faux ?
_.gif)

Le 13 décembre 2019 à 14:27:37 Jean-Passe-Hess a écrit :
Bordel les lillois vous arrivez encore à retenir de l'ue 7 ? Y'a plus rien qui rentre perso
Perso je retiens très facilement l’UE7 par contre l’UE5 c’est la mort.
J’ai vraiment du mal avec les trucs du genre « passe à gauche », « passe à droite » bla-bla-bla
Je suis dans la merde en anatomie.
Mais bon je pense vouloir pharma donc je m’en fous un peu.
Le 13 décembre 2019 à 19:57:29 -Eiween- a écrit :
Le 13 décembre 2019 à 14:27:37 Jean-Passe-Hess a écrit :
Bordel les lillois vous arrivez encore à retenir de l'ue 7 ? Y'a plus rien qui rentre perso
Perso je retiens très facilement l’UE7 par contre l’UE5 c’est la mort.
J’ai vraiment du mal avec les trucs du genre « passe à gauche », « passe à droite » bla-bla-blaJe suis dans la merde en anatomie.
Mais bon je pense vouloir pharma donc je m’en fous un peu.
Je suis carré et je vise aussi pharma 
Mais j'ai eu une sale note en anat et ça m'a fait perdre beaucoup de places 
Je retenais tout facilement aussi en UE 7 mais la mon cerveau sature 
Heureusement que c'est que coef 1 
Mais sinon le reste des UE ça va, et toi ?
Le 13 décembre 2019 à 20:02:31 Jean-Passe-Hess a écrit :
Le 13 décembre 2019 à 19:57:29 -Eiween- a écrit :
Le 13 décembre 2019 à 14:27:37 Jean-Passe-Hess a écrit :
Bordel les lillois vous arrivez encore à retenir de l'ue 7 ? Y'a plus rien qui rentre perso
Perso je retiens très facilement l’UE7 par contre l’UE5 c’est la mort.
J’ai vraiment du mal avec les trucs du genre « passe à gauche », « passe à droite » bla-bla-blaJe suis dans la merde en anatomie.
Mais bon je pense vouloir pharma donc je m’en fous un peu.Je suis carré et je vise aussi pharma
Mais j'ai eu une sale note en anat et ça m'a fait perdre beaucoup de places
Je retenais tout facilement aussi en UE 7 mais la mon cerveau sature
Heureusement que c'est que coef 1
Mais sinon le reste des UE ça va, et toi ?
Ça passe.
Je suis un peu en retard de partout mais ça reste léger et en primant je pense pas que je sois la seule. 
Quand je parle de retard je parle des révisions pas des cours je précise.
L’annee dernière pour pharma c’etait quoi la note du dernier en comptant la spé ?
 , c'était quoi à peu près la moyenne en anat, l'année dernière JPH ?
, c'était quoi à peu près la moyenne en anat, l'année dernière JPH ?Le 13 décembre 2019 à 20:51:18 Quinterette a écrit :
Moi aussi j'ai plus que du retard en anat, c'était quoi à peu près la moyenne en anat, l'année dernière JPH ?
si t’es à lille, ça sert à rien de comparer avec les schémas...
Ça va totalement changer les moyennes je pense.

Mais c'est pas le soucis pour le moment, il reste 3 jours et je compte bien en profiter pour terminer UE 5 et UE 7,j'espère que vous aussi

Bon courage à vous deux

Le 13 décembre 2019 à 21:09:07 Jean-Passe-Hess a écrit :
Aucune idée pour les moyennes en anat
Mais c'est pas le soucis pour le moment, il reste 3 jours et je compte bien en profiter pour terminer UE 5 et UE 7,j'espère que vous aussi
Bon courage à vous deux
Du coup tu m’as pas dit.
C’etait quoi la moyenne en pharma du dernier pris ? (note en pharma pas du tronc commun).
Le 13 décembre 2019 à 21:14:50 -Eiween- a écrit :
Le 13 décembre 2019 à 21:09:07 Jean-Passe-Hess a écrit :
Aucune idée pour les moyennes en anat
Mais c'est pas le soucis pour le moment, il reste 3 jours et je compte bien en profiter pour terminer UE 5 et UE 7,j'espère que vous aussi
Bon courage à vous deuxDu coup tu m’as pas dit.
C’etait quoi la moyenne en pharma du dernier pris ? (note en pharma pas du tronc commun).
Aucune idée vu que j'étais pas dedans )_.gif)
Mais regarde sur le site y'a l'analyse des résultats de chaque année tu trouveras ton bonheur
Le 13 décembre 2019 à 21:22:48 Jean-Passe-Hess a écrit :
Le 13 décembre 2019 à 21:14:50 -Eiween- a écrit :
Le 13 décembre 2019 à 21:09:07 Jean-Passe-Hess a écrit :
Aucune idée pour les moyennes en anat
Mais c'est pas le soucis pour le moment, il reste 3 jours et je compte bien en profiter pour terminer UE 5 et UE 7,j'espère que vous aussi
Bon courage à vous deuxDu coup tu m’as pas dit.
C’etait quoi la moyenne en pharma du dernier pris ? (note en pharma pas du tronc commun).Aucune idée vu que j'étais pas dedans
Mais regarde sur le site y'a l'analyse des résultats de chaque année tu trouveras ton bonheur
[16:36:07] <BM-smerch_>
J imagine un polynucléaires neutrophiles, car il est le seule à être comme ça sur l image, +gros noyaux désordonné. Dur d etre sure avec juste cette image, t as pas d autre detaille?
C'est bien ce que je me disais 
Faut savoir que les PNN ont un noyau avec entre 2 et 5 lobules tandis que les éosinophiles et les basophiles n'ont que 2 lobules 
Données du topic
- Auteur
- PenalTea3
- Date de création
- 18 juillet 2019 à 12:05:55
- Nb. messages archivés
- 11742
- Nb. messages JVC
- 11741
Afficher uniquement les messages de l'auteur du topic